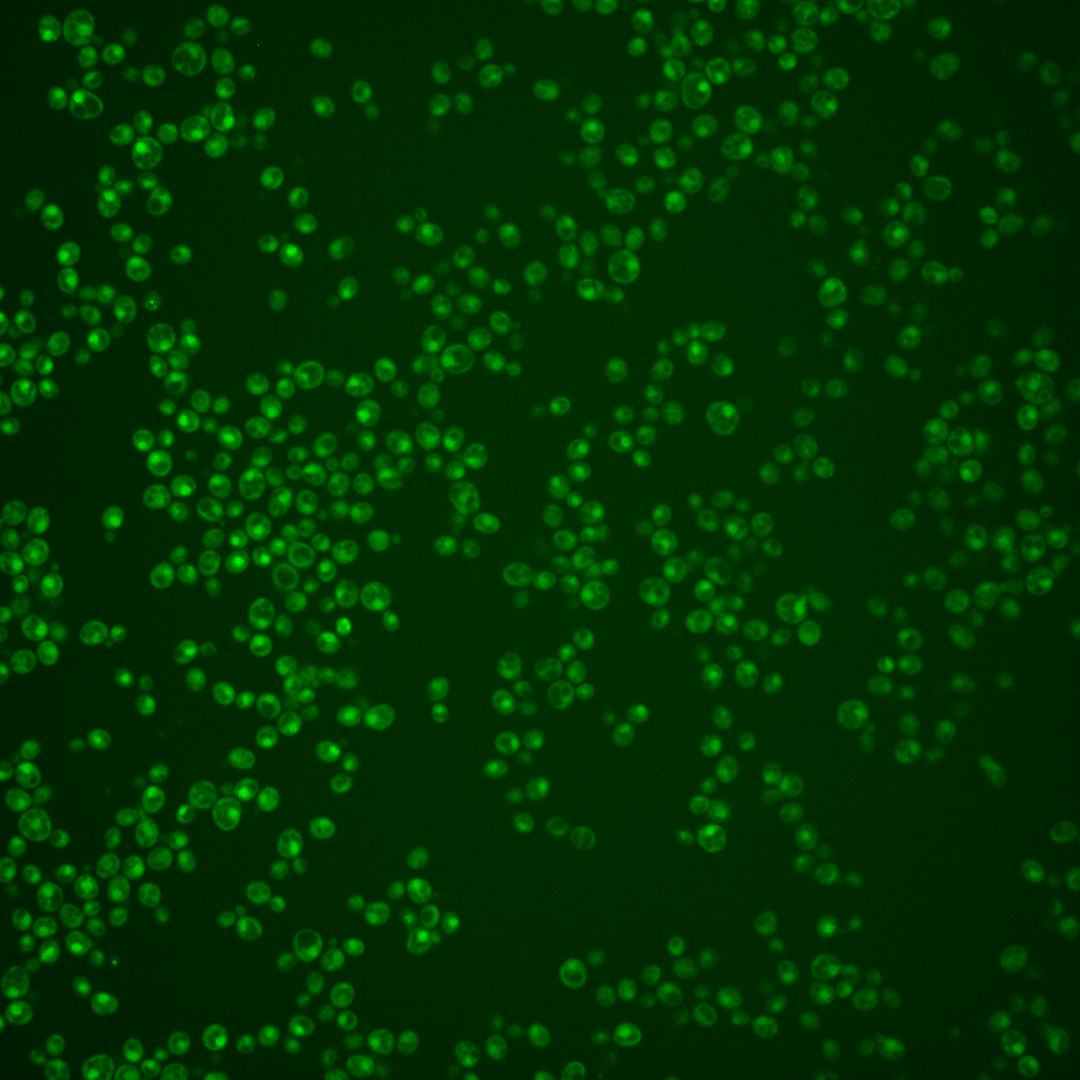
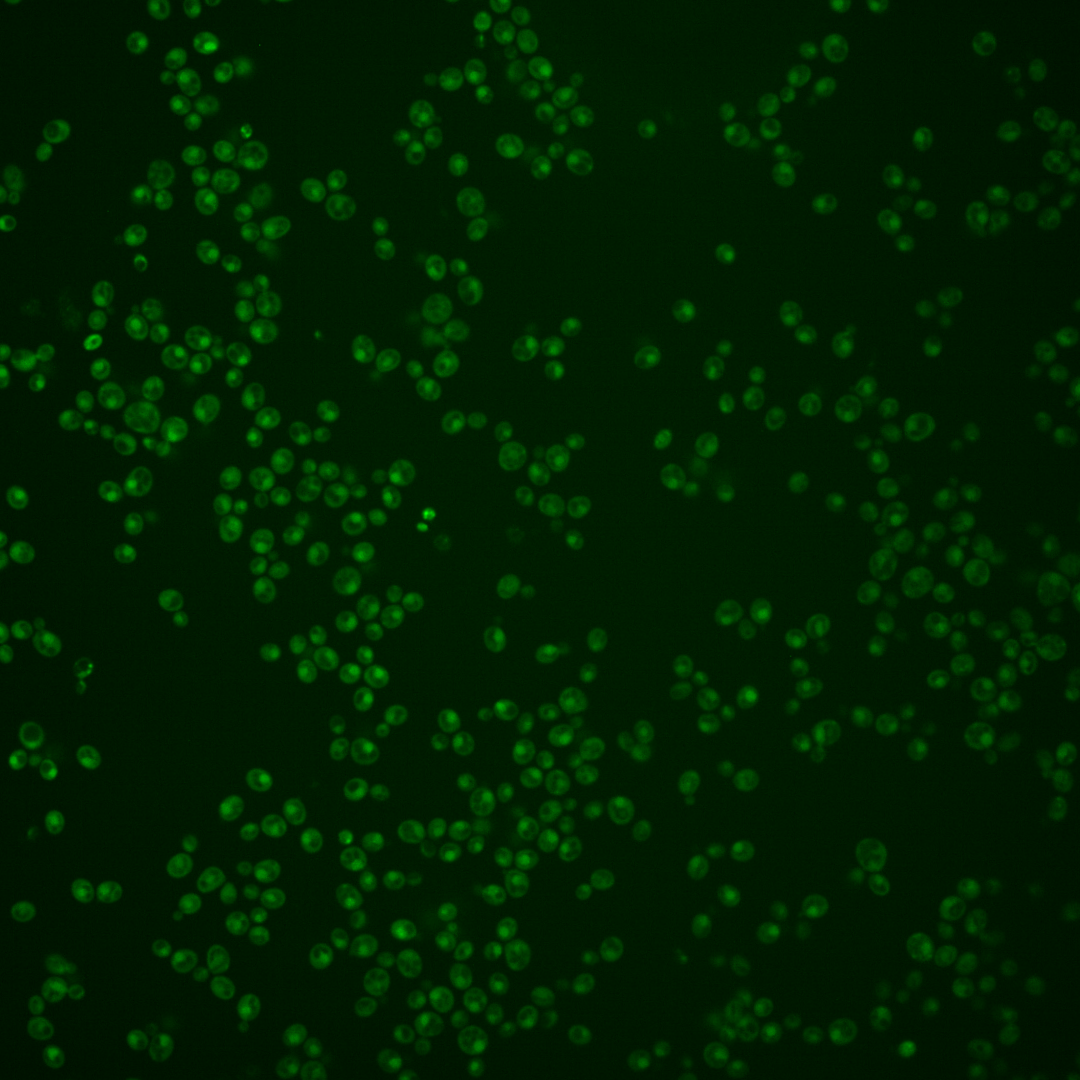
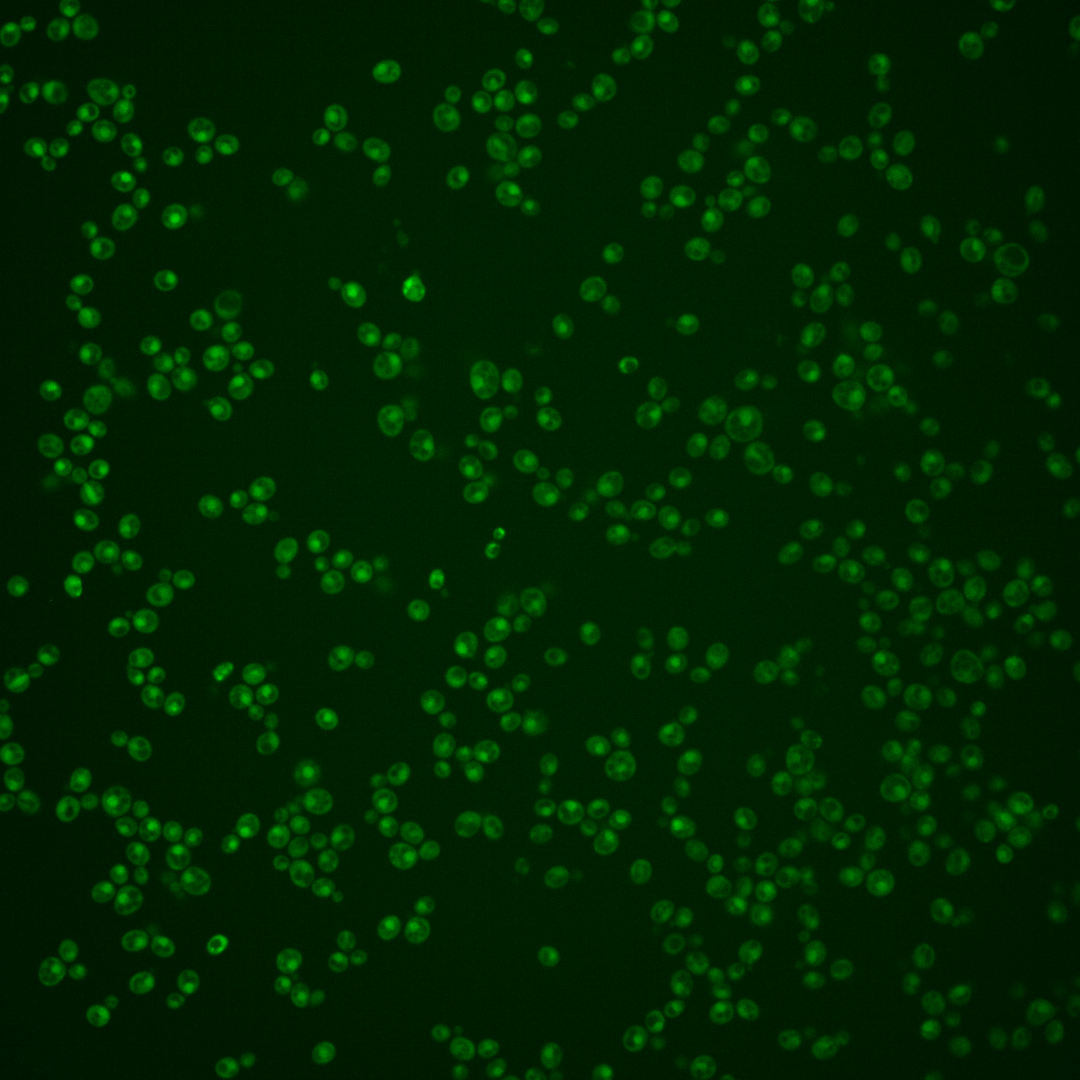
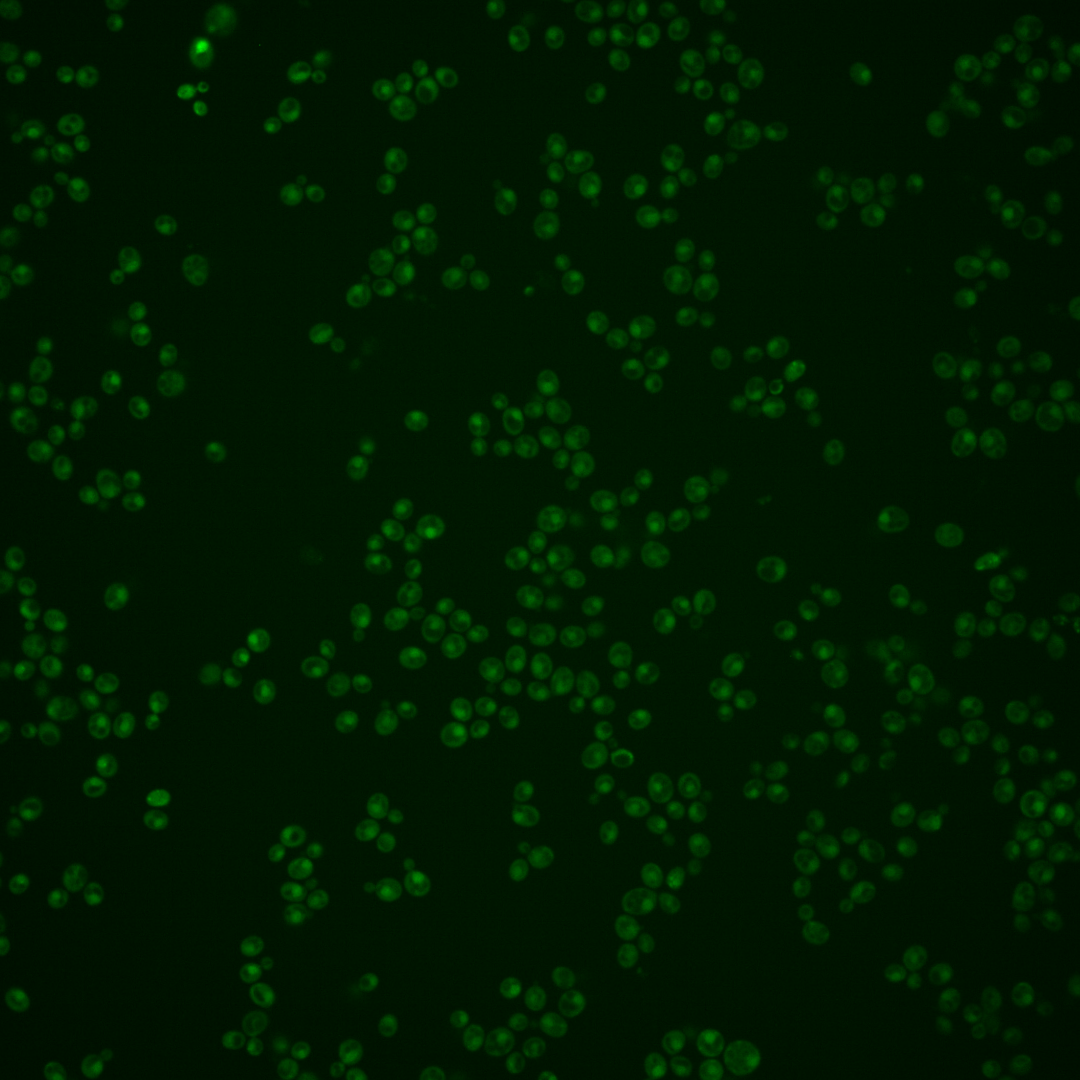

| Standard name | |
|---|---|
| Human Ortholog | |
| Description | Protein that binds to the Rap1p C-terminus; acts synergistically with Rif1p to help control telomere length and establish telomeric silencing; deletion results in telomere elongation; RIF2 has a paralog, ORC4, that arose from the whole genome duplication |
Micrographs




















































































Sub-cellular Localization
Yeast GFP Assignment
Protein Abundance
Localization Change
External localization resources
| ensLOC | DeepLoc | |||||||||||||||||||||||
|---|---|---|---|---|---|---|---|---|---|---|---|---|---|---|---|---|---|---|---|---|---|---|---|---|
| Localization | WT1 | WT2 | WT3 | RAP60 | RAP140 | RAP220 | RAP300 | RAP380 | RAP460 | RAP540 | RAP620 | RAP700 | HU80 | HU120 | HU160 | rpd3Δ_1 | rpd3Δ_2 | rpd3Δ_3 | WT1 | WT2 | WT3 | AF100 | AF140 | AF180 |
| Cortical Patches | 0 | 0 | 0 | 0 | 0 | 0 | 0 | 0 | 0 | 0 | 0 | 0 | 0 | 0 | 0 | 0 | 0 | 0 | 0 | 1 | 3 | 0 | 0 | 0 |
| Bud | 0 | 2 | 1 | 4 | 7 | 16 | 12 | 17 | 13 | 13 | 12 | 11 | 0 | 0 | 0 | 0 | 2 | 0 | 0 | 7 | 10 | 3 | 5 | 6 |
| Bud Neck | 0 | 1 | 0 | 0 | 1 | 0 | 0 | 1 | 1 | 0 | 0 | 0 | 2 | 1 | 0 | 0 | 0 | 0 | 0 | 0 | 2 | 2 | 1 | 3 |
| Bud Site | 0 | 1 | 0 | 0 | 2 | 6 | 8 | 5 | 7 | 11 | 13 | 14 | 0 | 0 | 0 | 0 | 0 | 0 | – | – | – | – | – | – |
| Cell Periphery | 0 | 0 | 0 | 0 | 0 | 0 | 0 | 0 | 0 | 0 | 1 | 1 | 0 | 0 | 0 | 0 | 0 | 1 | 0 | 0 | 0 | 0 | 0 | 0 |
| Cytoplasm | 26 | 36 | 85 | 67 | 59 | 78 | 75 | 136 | 61 | 79 | 77 | 56 | 53 | 68 | 101 | 73 | 137 | 110 | 19 | 42 | 62 | 47 | 56 | 68 |
| Endoplasmic Reticulum | 1 | 2 | 2 | 0 | 1 | 0 | 0 | 1 | 0 | 0 | 0 | 1 | 1 | 1 | 0 | 10 | 19 | 22 | 0 | 0 | 3 | 0 | 0 | 3 |
| Endosome | 0 | 0 | 20 | 12 | 10 | 3 | 3 | 13 | 6 | 9 | 10 | 2 | 3 | 3 | 8 | 3 | 18 | 14 | 1 | 5 | 13 | 0 | 6 | 8 |
| Golgi | 0 | 0 | 0 | 0 | 1 | 0 | 0 | 0 | 0 | 0 | 0 | 0 | 0 | 0 | 0 | 0 | 2 | 1 | 1 | 1 | 2 | 0 | 1 | 1 |
| Mitochondria | 108 | 68 | 41 | 48 | 99 | 323 | 380 | 378 | 282 | 365 | 332 | 447 | 2 | 1 | 0 | 2 | 37 | 9 | 6 | 7 | 41 | 10 | 16 | 18 |
| Nucleus | 72 | 129 | 88 | 84 | 73 | 144 | 165 | 207 | 161 | 158 | 138 | 164 | 145 | 155 | 125 | 88 | 130 | 121 | 93 | 184 | 131 | 76 | 85 | 93 |
| Nuclear Periphery | 1 | 0 | 2 | 2 | 2 | 4 | 1 | 2 | 9 | 10 | 4 | 15 | 0 | 0 | 0 | 0 | 0 | 0 | 2 | 1 | 6 | 0 | 0 | 2 |
| Nucleolus | 0 | 0 | 1 | 1 | 1 | 1 | 1 | 4 | 4 | 2 | 6 | 1 | 0 | 0 | 0 | 0 | 0 | 0 | 1 | 1 | 3 | 0 | 1 | 0 |
| Peroxisomes | 0 | 0 | 0 | 0 | 0 | 0 | 0 | 1 | 0 | 0 | 0 | 0 | 0 | 0 | 2 | 0 | 0 | 0 | 0 | 0 | 0 | 0 | 0 | 1 |
| SpindlePole | 0 | 1 | 0 | 4 | 2 | 3 | 2 | 3 | 10 | 5 | 2 | 4 | 2 | 2 | 2 | 1 | 5 | 1 | 7 | 12 | 14 | 8 | 11 | 13 |
| Vac/Vac Membrane | 21 | 74 | 54 | 39 | 55 | 57 | 39 | 77 | 42 | 55 | 65 | 51 | 10 | 20 | 22 | 54 | 138 | 109 | 51 | 77 | 104 | 64 | 95 | 108 |
| Unique Cell Count | 163 | 258 | 265 | 221 | 253 | 471 | 509 | 653 | 452 | 525 | 495 | 576 | 209 | 238 | 247 | 208 | 415 | 327 | 189 | 352 | 414 | 221 | 293 | 339 |
| Labelled Cell Count | 229 | 314 | 294 | 261 | 313 | 635 | 686 | 845 | 596 | 707 | 660 | 767 | 218 | 251 | 260 | 231 | 488 | 388 | 189 | 352 | 414 | 221 | 293 | 339 |
Yeast GFP Assignment
Protein Abundance
| Screen | WT1 | WT2 | WT3 | RAP60 | RAP140 | RAP220 | RAP300 | RAP380 | RAP460 | RAP540 | RAP620 | RAP700 | HU80 | HU120 | HU160 | rpd3Δ_1 | rpd3Δ_2 | rpd3Δ_3 | AF100 | AF140 | AF180 |
|---|---|---|---|---|---|---|---|---|---|---|---|---|---|---|---|---|---|---|---|---|---|
| Mean Cell GFP Intensity (1e-4) | 3.2 | 4.2 | 4.8 | 4.4 | 4.3 | 3.4 | 3.4 | 3.6 | 3.4 | 3.4 | 3.3 | 3.1 | 5.6 | 5.6 | 5.3 | 5.9 | 5.5 | 5.5 | 5.8 | 6.0 | 6.1 |
| Std Deviation (1e-4) | 0.5 | 0.6 | 2.3 | 2.1 | 1.9 | 1.2 | 1.4 | 1.8 | 0.8 | 0.7 | 1.1 | 0.5 | 1.0 | 1.0 | 1.0 | 1.5 | 1.2 | 1.3 | 1.5 | 1.4 | 1.2 |
| Intensity Change (Log2) | – | – | – | -0.13 | -0.18 | -0.5 | -0.5 | -0.45 | -0.52 | -0.53 | -0.57 | -0.65 | 0.21 | 0.2 | 0.13 | 0.29 | 0.18 | 0.18 | 0.26 | 0.3 | 0.33 |
Localization Change
| Localization | RAP60 | RAP140 | RAP220 | RAP300 | RAP380 | RAP460 | RAP540 | RAP620 | RAP700 | HU80 | HU120 | HU160 | rpd3Δ_1 | rpd3Δ_2 | rpd3Δ_3 |
|---|---|---|---|---|---|---|---|---|---|---|---|---|---|---|---|
| Actin | – | – | – | – | – | – | – | – | – | – | – | – | – | – | – |
| Bud | – | – | – | – | – | – | – | – | – | – | – | – | 0 | 0 | 0 |
| Bud Neck | – | – | – | – | – | – | – | – | – | – | – | – | 0 | 0 | 0 |
| Bud Site | – | – | – | – | – | – | – | – | – | – | – | – | 0 | 0 | 0 |
| Cell Periphery | – | – | – | – | – | – | – | – | – | – | – | – | 0 | 0 | 0 |
| Cyto | – | – | – | – | – | – | – | – | – | – | – | – | – | – | – |
| Endoplasmic Reticulum | – | – | – | – | – | – | – | – | – | – | – | – | 0 | 0 | 0 |
| Endosome | – | – | – | – | – | – | – | – | – | – | – | – | 0 | 0 | 0 |
| Golgi | – | – | – | – | – | – | – | – | – | – | – | – | 0 | 0 | 0 |
| Mitochondria | – | – | – | – | – | – | – | – | – | – | – | – | 0 | 0 | 0 |
| Nuclear Periphery | – | – | – | – | – | – | – | – | – | – | – | – | 0 | 0 | 0 |
| Nuc | – | – | – | – | – | – | – | – | – | – | – | – | – | – | – |
| Nucleolus | – | – | – | – | – | – | – | – | – | – | – | – | 0 | 0 | 0 |
| Peroxisomes | – | – | – | – | – | – | – | – | – | – | – | – | 0 | 0 | 0 |
| SpindlePole | – | – | – | – | – | – | – | – | – | – | – | – | 0 | 0 | 0 |
| Vac | – | – | – | – | – | – | – | – | – | – | – | – | – | – | – |
| Cortical Patches | – | – | – | – | – | – | – | – | – | – | – | – | 0 | 0 | 0 |
| Cytoplasm | – | – | – | – | – | – | – | – | – | – | – | – | 0 | 0 | 0 |
| Nucleus | – | – | – | – | – | – | – | – | – | – | – | – | 0 | 0 | 0 |
| Vacuole | – | – | – | – | – | – | – | – | – | – | – | – | 1.4 | 3.6 | 3.5 |
External localization resources
Images






























Protein Concentration and Protein Localization Data
| R1 | R2 | R3 | ||||||||||||||||
|---|---|---|---|---|---|---|---|---|---|---|---|---|---|---|---|---|---|---|
| G1 Pre-START | G1 Post-START | S/G2 | Metaphase | Anaphase | Telophase | G1 Pre-START | G1 Post-START | S/G2 | Metaphase | Anaphase | Telophase | G1 Pre-START | G1 Post-START | S/G2 | Metaphase | Anaphase | Telophase | |
| Concentration | 0.9415 | 1.0479 | 0.8857 | 1.0334 | 1.2634 | 0.776 | 1.562 | 1.3729 | 1.3812 | 0.9395 | 2.4262 | 1.1495 | 0.9574 | 0.3271 | 0.1617 | 0.9894 | 0.5251 | 0.345 |
| Actin | 0.0134 | 0.0005 | 0.0048 | 0.0245 | 0.052 | 0.0006 | 0.0106 | 0.0002 | 0.0047 | 0.0062 | 0.0254 | 0.0023 | 0.023 | 0.0014 | 0.0105 | 0.0097 | 0.0129 | 0.0042 |
| Bud | 0.0007 | 0.0001 | 0.0001 | 0.0002 | 0.0003 | 0.0009 | 0.0008 | 0.0001 | 0.0003 | 0.0004 | 0.0005 | 0.0001 | 0.0015 | 0.0001 | 0.0001 | 0.0017 | 0.0121 | 0.0004 |
| Bud Neck | 0.0064 | 0.0008 | 0.0004 | 0.0011 | 0.0032 | 0.0025 | 0.0051 | 0.0004 | 0.0049 | 0.001 | 0.0114 | 0.0017 | 0.0106 | 0.0007 | 0.0007 | 0.0031 | 0.0054 | 0.0025 |
| Bud Periphery | 0.001 | 0.0001 | 0.0002 | 0.0002 | 0.0005 | 0.0003 | 0.0023 | 0.0001 | 0.0007 | 0.0011 | 0.0015 | 0.0001 | 0.0032 | 0.0001 | 0.0001 | 0.0063 | 0.002 | 0.0003 |
| Bud Site | 0.0021 | 0.0016 | 0.0005 | 0.0051 | 0.0013 | 0.0005 | 0.0026 | 0.0007 | 0.0024 | 0.0005 | 0.0016 | 0.0001 | 0.0057 | 0.0005 | 0.0002 | 0.0115 | 0.0066 | 0.0014 |
| Cell Periphery | 0.0002 | 0.0001 | 0 | 0.0002 | 0.0002 | 0 | 0.0004 | 0 | 0.0001 | 0.0001 | 0.0004 | 0 | 0.0003 | 0 | 0 | 0.0004 | 0.0003 | 0 |
| Cytoplasm | 0.0411 | 0.0608 | 0.0401 | 0.0683 | 0.0115 | 0.0446 | 0.0512 | 0.0715 | 0.0437 | 0.0268 | 0.0488 | 0.0356 | 0.0394 | 0.0475 | 0.0414 | 0.0362 | 0.0348 | 0.0237 |
| Cytoplasmic Foci | 0.0123 | 0.0045 | 0.0045 | 0.0094 | 0.0149 | 0.0027 | 0.0073 | 0.0018 | 0.0028 | 0.0026 | 0.0125 | 0.0021 | 0.0127 | 0.0008 | 0.0018 | 0.0026 | 0.0102 | 0.0019 |
| Eisosomes | 0.0004 | 0.0001 | 0.0002 | 0.0002 | 0.0007 | 0 | 0.0002 | 0 | 0.0001 | 0.0001 | 0.0005 | 0 | 0.0002 | 0 | 0.0001 | 0.0003 | 0.0002 | 0 |
| Endoplasmic Reticulum | 0.0026 | 0.0028 | 0.0017 | 0.006 | 0.0018 | 0.0008 | 0.0037 | 0.0021 | 0.0031 | 0.002 | 0.005 | 0.0016 | 0.0055 | 0.0025 | 0.0012 | 0.0022 | 0.0031 | 0.0011 |
| Endosome | 0.014 | 0.0026 | 0.0042 | 0.0165 | 0.0081 | 0.0019 | 0.0157 | 0.0017 | 0.0048 | 0.0118 | 0.0247 | 0.0032 | 0.0196 | 0.0019 | 0.0022 | 0.0064 | 0.0066 | 0.0031 |
| Golgi | 0.0021 | 0.0001 | 0.0012 | 0.0038 | 0.0083 | 0.0001 | 0.0029 | 0.0001 | 0.0011 | 0.0055 | 0.0083 | 0.0004 | 0.0048 | 0.0002 | 0.0014 | 0.0024 | 0.0023 | 0.0013 |
| Lipid Particles | 0.0055 | 0.0004 | 0.0027 | 0.0045 | 0.0142 | 0.0003 | 0.0134 | 0.0001 | 0.002 | 0.0102 | 0.0248 | 0.0017 | 0.011 | 0.0002 | 0.008 | 0.0026 | 0.0036 | 0.0027 |
| Mitochondria | 0.0024 | 0.0011 | 0.0023 | 0.0018 | 0.0046 | 0.0005 | 0.011 | 0.0005 | 0.0013 | 0.0153 | 0.0181 | 0.0008 | 0.0072 | 0.0008 | 0.0018 | 0.0127 | 0.003 | 0.0015 |
| None | 0.0821 | 0.1237 | 0.1335 | 0.1075 | 0.0668 | 0.09 | 0.0353 | 0.0979 | 0.0349 | 0.0729 | 0.111 | 0.0274 | 0.0768 | 0.0712 | 0.1026 | 0.0947 | 0.0555 | 0.0478 |
| Nuclear Periphery | 0.0433 | 0.0499 | 0.0448 | 0.0669 | 0.0212 | 0.022 | 0.0341 | 0.0208 | 0.0339 | 0.0133 | 0.0837 | 0.0185 | 0.0409 | 0.0456 | 0.0399 | 0.0175 | 0.0743 | 0.0169 |
| Nucleolus | 0.0085 | 0.0097 | 0.0075 | 0.0078 | 0.0264 | 0.0122 | 0.0083 | 0.0068 | 0.0046 | 0.0059 | 0.0086 | 0.0086 | 0.0095 | 0.0063 | 0.0054 | 0.0155 | 0.0096 | 0.0101 |
| Nucleus | 0.6771 | 0.6569 | 0.6727 | 0.5056 | 0.6324 | 0.6978 | 0.7145 | 0.7296 | 0.8042 | 0.7682 | 0.5144 | 0.8019 | 0.6509 | 0.7521 | 0.722 | 0.7209 | 0.7231 | 0.8185 |
| Peroxisomes | 0.0037 | 0.0002 | 0.004 | 0.0017 | 0.0117 | 0.0005 | 0.0046 | 0.0001 | 0.001 | 0.0029 | 0.0125 | 0.0016 | 0.0056 | 0.0001 | 0.0005 | 0.0013 | 0.0037 | 0.0074 |
| Punctate Nuclear | 0.0786 | 0.082 | 0.0731 | 0.1666 | 0.1177 | 0.1208 | 0.0702 | 0.0638 | 0.0471 | 0.0511 | 0.0772 | 0.0911 | 0.0659 | 0.0657 | 0.0592 | 0.0473 | 0.0281 | 0.0543 |
| Vacuole | 0.0014 | 0.0015 | 0.0008 | 0.0012 | 0.001 | 0.0004 | 0.0037 | 0.0012 | 0.0016 | 0.0012 | 0.005 | 0.001 | 0.0036 | 0.0014 | 0.0005 | 0.0032 | 0.0015 | 0.0005 |
| Vacuole Periphery | 0.001 | 0.0006 | 0.0005 | 0.0007 | 0.001 | 0.0003 | 0.0019 | 0.0003 | 0.0009 | 0.0009 | 0.0042 | 0.0003 | 0.0019 | 0.0007 | 0.0005 | 0.0015 | 0.0012 | 0.0003 |
Sequencing Data
| R1 | R2 | |||||||||
|---|---|---|---|---|---|---|---|---|---|---|
| G1 Post-START | S/G2 | Metaphase | Anaphase | Telophase | G1 Post-START | S/G2 | Metaphase | Anaphase | Telophase | |
| Gene Expression | 6.0371 | 8.3028 | 3.0805 | 5.3404 | 6.6232 | 4.6414 | 5.2469 | 6.2327 | 3.5492 | 5.9255 |
| Translational Efficiency | 0.4821 | 0.3315 | 0.6885 | 0.3848 | 0.3353 | 0.9275 | 0.5936 | 0.6446 | 0.7446 | 0.6372 |
Hit Data
| Dataset | Hit |
|---|---|
| Protein Concentration | ✔ |
| Protein Localization | ✘ |
| Gene Expression | ✘ |
| Translational Efficiency | ✘ |
Endocytosis
| Temp | Actin Patch (Sac6-tdTomato) | Cortical Patch (Sla1-GFP) | Late Endosome (Snf7-GFP) | Vacuole (Vph1-GFP) |
|---|---|---|---|---|
| 37℃ | ||||
| RT |
Cell Cycle Omics
CYCLoPs (Rif2-GFP)
| Gene / Allele | Actin Patch (Sac6-tdTomato) | Cortical Patch (Sla1-GFP) | Late Endosome (Snf7-GFP) | Vacuole (Sac6-tdTomato) |
|---|
| Gene | Images |
|---|
| Gene | Images |
|---|
Images are not yet available
Images are not yet available